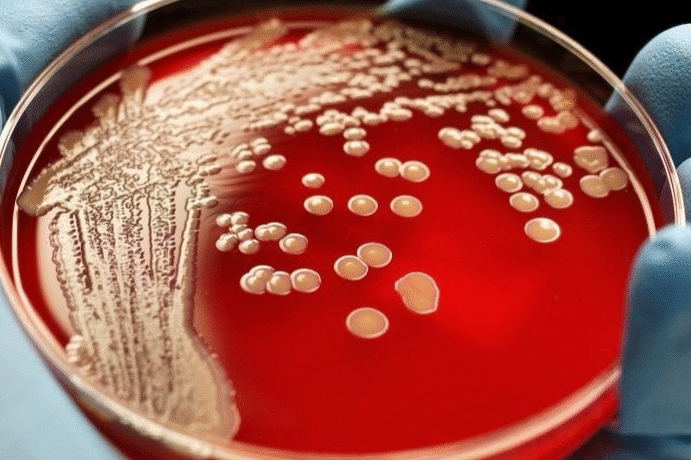

Гепатит А, також відомий як хвороба Боткіна, є гострим інфекційним захворюванням печінки, спричиненим вірусом гепатиту А (HAV). Передається переважно фекально-оральним шляхом і супроводжується симптомами загальної інтоксикації, ураженням печінки та порушенням обміну білірубіну. Незважаючи на те, що гепатит А частіше має сприятливий перебіг, ускладнення у вигляді дискінезії жовчовивідних шляхів, холециститу та затяжної форми захворювання трапляються дедалі частіше. Сучасний підхід у клініці “Альтернатива” передбачає інтеграцію методів озонотерапії з базовою медикаментозною терапією, що дозволяє значно підвищити ефективність лікування, прискорити відновлення та знизити ймовірність ускладнень.
Теоретичне обґрунтування комбінованого підходу
Медикаментозне лікування гепатиту А включає дезінтоксикаційну терапію, гепатопротектори, спазмолітики та вітаміни групи B. Проте вірусне навантаження та супутній запальний процес вимагають комплексного впливу на організм. Озонотерапія, завдяки вираженому противірусному, протизапальному, детоксикаційному та імуномодулюючому ефекту, посилює дію медикаментозних препаратів, скорочує тривалість захворювання та запобігає розвитку ускладнень.
Методи озонотерапії при гепатиті А в МЦ “Альтернатива”
У клініці “Альтернатива” застосовуються такі методи озонотерапії при лікуванні гепатиту А:
- Внутрішньовенне введення озонованого фізрозчину сприяє прискореній детоксикації організму, нормалізує обмін речовин у гепатоцитах і активує антиоксидантний захист.
- Велика аутогемозонотерапія (ВАГОТ) активує імунітет, зменшує вірусне навантаження, покращує реологію крові та сприяє відновленню клітин печінки.
- Санація ЛОР-органів озоно-кисневою сумішшю – профілактика та усунення вторинних осередків хронічної інфекції, які посилюють запальний фон та інтоксикацію.
- Ректальні інсуфляції озоно-кисневою сумішшю впливають на венозну систему малого таза та кишківник, сприяючи нормалізації мікрофлори та зниженню рівня системного запалення.
- Прийом озонованої води покращує гідратацію, сприяє виведенню токсинів, чинить м’який антиоксидантний ефект.
- Мікроклізми з озонованим маслом покращують регенерацію слизової оболонки кишківника, усувають запалення та покращують засвоєння вітамінів.
- Прийом озонованого масла внутрішньо чинить противірусну та гепатопротекторну дію, сприяє відновленню функції печінки.
- Газування тіла (кінцівок) озоно-кисневою сумішшю в пластиковому мішку покращує трофіку тканин, активує лімфатичну систему та знижує рівень набряків.
- Обколювання озоно-кисневою сумішшю (місцеві ін’єкції) знімає локальні запальні процеси та покращує кровопостачання певних зон.
- Зовнішнє застосування озонованого масла при наявності шкірних проявів (жовтяничний свербіж, алергічні реакції).
- Вагінальні інсуфляції озоно-кисневою сумішшю при необхідності санації статевих шляхів, особливо у жінок із супутніми хронічними запаленнями.
Клінічні результати комбінованої терапії при лікуванні гепатиту А
За даними спостережень у центрі «Альтернатива», при використанні озонотерапії у комплексі з базовою медикаментозною підтримкою були досягнуті значні клінічні покращення за низкою ключових показників:
- Скорочення часу нормалізації білірубіну в 2 рази порівняно з пацієнтами, які отримували виключно медикаментозну терапію, що особливо важливо за наявності ознак холестазу та білірубінової інтоксикації.
- Прискорене зниження рівня АЛТ і АСТ, що свідчить про ефективний захист гепатоцитів, відновлення клітинної мембрани печінки та загальне покращення функції детоксикації організму.
- Зниження вираженості синдрому інтоксикації (слабкість, головний біль, нудота, відсутність апетиту, ломота в тілі) на 3–4 дні швидше, ніж при стандартному лікуванні.
- Зниження частоти розвитку ускладнень, таких як дискінезія жовчовивідних шляхів, реактивний холецистит, вторинний панкреатит і дуоденогастральний рефлюкс, завдяки стабілізації відтоку жовчі та протизапальному ефекту озону.
- Покращення загального самопочуття та настрою пацієнтів уже на 2–3 день після початку комплексної терапії, що зумовлено покращенням оксигенації тканин і зниженням навантаження на центральну нервову систему.
- Нормалізація стільця та відновлення травної функції у 87% пацієнтів до кінця першого тижня терапії, що особливо важливо за супутнього синдрому подразненого кишківника або постгепатитних функціональних розладів.
- Відновлення нормального сну та апетиту відзначалося у більш ніж 90% пацієнтів, особливо у дітей і людей похилого віку, завдяки седативному та регуляторному ефекту озону на гіпоталамо-гіпофізарну систему.
- Покращення показників імунної відповіді, таких як нормалізація рівня лейкоцитів, зниження запальних маркерів (СРБ, ШОЕ), посилення фагоцитарної активності, що знижує ризик приєднання вторинних інфекцій.
- Швидше відновлення біохімічних і гематологічних параметрів крові, включаючи нормалізацію рівня холестерину, глюкози, феритину та лужної фосфатази.
- Підвищення життєвого тонусу та переносимості фізичних навантажень, особливо у пацієнтів із хронічною втомою та тривалим постінфекційним синдромом.
Також варто зазначити, що комбінована терапія із застосуванням озону продемонструвала високу безпеку та добру переносимість: не було зафіксовано серйозних побічних реакцій, а суб’єктивне покращення стану відзначалося вже після 1–2 процедур.
Приклад клінічного випадку
Пацієнтка, 28 років, діагноз: гепатит А середньої тяжкості. При поступленні скаржилася на виражену слабкість, нудоту, болі в правому підребер’ї, жовтяничність шкіри та склер, шкірний свербіж. Білірубін загальний — 190 мкмоль/л, АЛТ — 720 Од/л, АСТ — 590 Од/л. Лікування включало: крапельниці з озонованим фізрозчином, ВАГОТ 3 рази на тиждень, прийом озонованої води, озонованого масла, ректальні інсуфляції та санацію ЛОР-органів. На 5-й день терапії відзначалося зниження білірубіну до 100 мкмоль/л, АЛТ — до 280 Од/л. До 10 дня — повна нормалізація біохімічних показників і зникнення клінічних симптомів. Пацієнтку виписано на 12 день без ознак залишкової інтоксикації.
Методи озонотерапії, що застосовуються в клініці “Альтернатива”, проводяться строго за показаннями, під контролем фахівців.
Озонотерапія має високий профіль безпеки, проте є низка відносних протипоказань: тиреотоксикоз, тромбоцитопенія, гострі психічні розлади, алергія на озон. Усі пацієнти проходять попереднє обстеження перед початком терапії.
Комбінований підхід, що включає медикаментозну терапію та озонотерапію, дозволяє досягти кращих клінічних результатів при лікуванні гепатиту А. Методи озонотерапії, застосовувані в медичному центрі “Альтернатива”, чинять комплексний вплив: знижують вірусне та токсичне навантаження, стимулюють імунну систему та сприяють регенерації гепатоцитів. Своєчасне та індивідуалізоване застосування цих методів значно прискорює відновлення пацієнта, знижує ризик ускладнень і підвищує якість життя в період хвороби та після одужання.

Лікування гепатиту А з озонотерапією стало для мене справжнім порятунком. Після кількох сеансів я відчула полегшення, зникла нудота, повернулася енергія. Лікарі все детально пояснили, процедура безпечна. Дуже задоволена результатом!